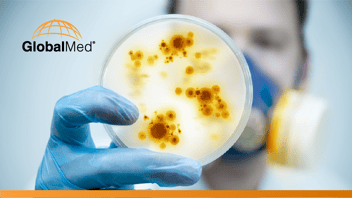

Here’s what’s great about telemedicine: it can benefit multiple healthcare players at once. So often experience and cynicism have trained us to think of healthcare as a zero-sum game, where expanded market offerings for some patients drive up insurance premiums for others, or a payer’s cost savings program
increases the documentation burden on providers.
Here’s what’s great about telemedicine: it can benefit multiple healthcare players at once. So often experience and cynicism have trained us to think of healthcare as a zero-sum game, where expanded market offerings for some patients drive up insurance premiums for others, or a payer’s cost savings program
increases the documentation burden on providers.
But telemedicine is different. Because it can address so many challenges at once – provider shortages, care gaps, skyrocketing costs, physician burnout, as well as pandemic exposure , just to name a few – it can form a mutually advantageous bridge between partnering healthcare organizations.
We’ve seen a lot of this lately with provider networks and the hospitals they work with. A few years ago, a patient visiting a rural hospital with cardiac symptoms might have been transferred to a larger medical center for an invasive diagnostic procedure; today, a cardiologist can beam in remotely for a consultation to determine if that procedure is necessary. A patient with a painful mobility issue such as Parkinson’s disease can virtually see a rheumatologist from his PCP’s office instead of a cumbersome visit to a distant clinic. A patient with COVID-19 symptoms can virtually see a physician, without burdening an ER, to determine if hospital visit is necessary.
This isn’t a theoretical future; it’s the healthcare industry’s present reality – and it’s something we get asked about a lot. Leaders aren’t always sure how to connect both ends of the relationship, from the hospital looking for specialty providers to the provider networks contracting out their services.
Lending a Helping Hand to Hospitals
First let’s look at how these provider networks work without telemedicine. Essentially, they contract with doctors of various specialties and connect them to temporary staffing assignments – wherever they’re needed most. Maybe a small-town hospital can’t afford a full-time endocrinologist or they have trouble attracting physicians to their rural community. Maybe they’re dealing with a rising opioid epidemic in the area, an increase in COVID-19 cases, or a salmonella outbreak. At this point, the network will send out a provider, who we’ll call Dr. Smith, for a weeks-long rotation. Dr. Smith will stay in a hotel or short-term housing, with those expenses added to the network’s quote for her services.
Right away you can see several troubles here. The longer Dr. Smith stays in a hotel, the higher her provider network’s quote will be – which makes it hard to keep their rates competitive. She may have a tough time building a rapport with her fellow clinicians since she’s always changing assignments. And the patients? They can’t count on a long-term relationship with Dr. Smith, the doctor before her or the doctor who arrives after her. They want to see a consistent provider they can build trust with. As for Dr. Smith, eventually she tires of spending weeks on end in towns where she doesn’t know anyone – and she leaves the provider network for a staff position.
But add telemedicine to the equation and everything looks quite different.
Provider Network Telemedicine in Action
Now let’s see how one U.S. provider network operates with telemedicine. Their scope is national; they partner with healthcare facilities through small physician teams whose assignments are based on region and specialty. While those specialties span the full range of clinical disciplines, the most in demand are telestroke, tele-ICU, telecardiology, tele-ID and telepsych.
Here are a few ways this partnership plays out:
Nocturnal coverage. The remote providers diagnose and treat patients overnight so overworked staff physicians don’t need to be interrupted at home.
Clinical backup. Physicians and PAs virtually participate in rounds to support the on-site clinical team.
Smarter capacity management. Highlighted amid this pandemic, virtual providers can assist with patient admits and alleviate emergency department bottlenecks and long waiting times.
Intensive care support. They can help with the currently exponentially rising patient volumes, particularly in ICU and other units where there’s a shortage of intensivists and specialists.
Better patient experiences. Patients can stay in their communities, without unnecessary transfers or arduous travel, potentially helping to limit the spread of COVID-19.
In other words, the provider network can augment coverage, improve patient care, relieve provider burnout and keep patients close to their families. They also offer affordable and competitive pricing for their services. But those are the benefits to the hospital and patient. What about Dr. Smith – how do she and her provider network benefit from telemedicine?
Cost Savings, Consistent Care
Virtual care can help provider networks in several ways:
- Providers can limit their exposure to highly contagious diseases. As COVID-19 exponentially spreads across communities, virtual visits allow providers to see patients without risking their own health.
- They can take advantage of provider shortages. Yes, they already do this – but because telemedicine is virtual, the network can cast a wider net in terms of regional coverage. They can also recruit top talent, since their physicians can live anywhere.
- Providers can limit their time on the road, enjoying more satisfying work-life balance. Instead of being trapped in strange towns for weeks on end, they can work from their regular environment and maintain their normal routines.
- The provider network can better control their costs and lower their quotes when contracting with hospitals. Without any hotel bills to pay, they can offer a more fiscally attractive option over competitors.
- Because they no longer have a short-term expiration date on their assignments, providers can sustain consistent clinical relationships with both their colleagues and patients.
- Providers can also provide services to multiple hospitals or locations on different contracts in the same time span – increasing their productivity and billable hours for the network.
Expanding the Horizons of Care
Finally, let’s not forget the real beneficiaries of these arrangements: the patients. Adding agility into any healthcare organization, whether it’s a small clinic, a major hospital system or a provider network, means more – and often better – care options. This is especially true in regions with limited resources, where the addition of a new specialist or extra ICU support can dramatically change outcomes on an individual basis. With the current pandemic, offering virtual visits to patients can additionally help control the Coronavirus. Virtualizing provider networks extends these possibilities with a speed and versatility that changes the game for everyone.[nectar_cta btn_style=”see-through” heading_tag=”h6″ text_color=”#493b70″ button_color=”default” link_type=”regular” alignment=”left” alignment_tablet=”default” alignment_phone=”default” display=”block” text=”Now more than ever, telemedicine is more accessible and affordable.” link_text=”Contact us to learn more.” url=”http://globalmed.com/schedule-a-demo/”]For more information on how telemedicine can benefit your provider network, read our quick guide on how GlobalMed partners with provider networks to design evidence-based virtual programs and connect them with hospital clients. [image_with_animation image_url=”7717″ animation=”Fade In” hover_animation=”none” alignment=”” border_radius=”none” box_shadow=”none” image_loading=”default” max_width=”100%” max_width_mobile=”default” img_link=”http://globalmed.com/wp-content/uploads/2020/03/Provider-Group_1Pager.pdf”]